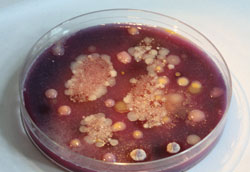
MT Aug 2013 Park Fig 1

DIY biology: bio-inspired or biohazard?
Do-it-yourself (DIY) biology is a rapidly growing global movement in which individuals, or small informal groups, seek to experiment with and also promote public access to biotechnology.
Depending on their particular approaches and background, these amateur biologists might call themselves ‘biohackers’ or ‘bioartists’ and their activities might include building their own low-cost laboratory equipment (microscopes, centrifuges, PCR machines) and attempting to perform experiments and research that would normally be confined to academic or industrial environments.
Emphasising its ‘do-it-yourself’ credentials, DIY biology is often carried out with little financial resource, by individuals with little or no formal training, in the absence of oversight by professionals, and mostly outside of governmental regulation and legislation. The specific aims of DIY biology’s participants are manifold, ranging from simply allowing easy access to the wonder of this science, to making political statements and challenging what some see as overly prohibitive legislation. Indeed, there seems to be no limit to the ambition of these projects with one group imagining a future where ‘self-aware citizens may manage their own stem cells, grow them in the garage and store them in the fridge’.

General Kitchen Agar (GKA), the most widely used medium for DIY microbiology. GKA is a novel modification of Plate Count Agar. It is made from ingredients available at supermarkets and can be used for the growth of a wide range of bacteria.
DIY biology inevitably interfaces with microbiology and it is here that it can add great benefit to outreach and engagement, but also gives rise to significant concerns and criticisms. There are a number of excellent examples of DIY biology practice. Genspace is a non-profit laboratory in New York that is open to members of the public and promotes education in molecular biology using DIY biology. At a cost of €4,000, Cathal Garvey has converted a bedroom at his home in Cork, Ireland, into a Containment Level 1 laboratory. Manchester’s Madlab host the UK’s largest DIY biology group who regularly run engaging public workshops that feature many aspects of DIY microbiology. My own small contribution to this field is Microbiology at Home: a short non-laboratory manual for enthusiasts and bioartists, a manual of methods for making various microbiological media at home with ingredients that are readily available at supermarkets.

Cyanobacterial Kitchen Agar (CKA), a medium for the isolation and growth of cyanobacteria. It is made from ingredients available at supermarkets and garden centres.
DIY biology does, however, suffer from a number of criticisms related to issues of safety, its scope and how it is reported. The dispersed and unregulated nature of the work gives rise to concerns that an individual or group might attempt to deliberately or inadvertently grow and release harmful biological agents. Additionally, where DIY genetic modification is being performed in an unregulated environment, there is a real danger that genetically modified organisms (GMOs) may be released into the environment. The examples of this type of DIY biology that I have seen for myself involve simple self-cloning and transformation with plasmids that are exempted from all of the GMO containment/use requirements. Nevertheless, persons undertaking these activities are still required to ensure that exposure of humans and the environment to the GMO is reduced to the lowest level that is reasonably practicable and to work under the general principles of good microbiological practice and occupational safety. This is clearly not the case in some of the examples that I have witnessed, with, for example, food and drink being stored and eaten in the same spaces where these experiments are being carried out. These safety concerns mean that DIY biology is now attracting the interests of governments. The prospect of ‘biohackers’ creating pathogens and GMOs in unmonitored garage laboratories led the Federal Bureau of Investigation (FBI) to begin sending representatives from its directorate for weapons of mass destruction to DIY biology conferences in 2009 and, in 2012, the FBI even invited and paid for the flights of around 60 of the most prominent figures within the DIY biology movement from across the world to a 3-day FBI-organised conference in California.
As a scientist, I see a great deal of hyperbole and over-enthusiastic reporting about DIY biology. At the moment, there is a vast chasm in the possibilities available to an amateur biologist, compared to someone with access to a traditional laboratory. I don’t want to dismiss DIY biologists or to suggest that you need to be highly trained to be able to do this properly, but with the resources available at present, there has been little meaningful scientific impact from the widespread use of biological technology that the early pioneers promised. I’m not seeking to belittle the DIY biologists but compared to my experiences within various scientific institutions I see much of their practice as ‘bio-tinkering’, which is not to mean that their work is without merit. At their worst, DIY biology activities can trivialise the scientific endeavour that preceded them and can also give rise to potentially damaging misinformation in their search for sensationalism.

The preparation of Cyanobacterial Kitchen Agar (CKA).
DIY biology and the scope of some of its claims have acquired considerable momentum through the advent of synthetic biology. The art world views some examples of DIY biology very differently to scientists, but I find some of these particularly troubling, such as ‘The Cactus Project’, an artwork based on a transgenic cactus that allegedly makes use of Agrobacterium-mediated gene transfer to introduce hair keratin genes into its cells. As a scientist, I immediately see the resulting hairy cactus as a hoax, but I suspect that many artists and members of the public do not view it as such. Tuur Van Balen’s ‘Pigeon d’Or’ project involved the creation of a genetically modified Lactobacillus species that produces soap, which he proposes to introduce into feral pigeons, to enable them to defecate soap. This is a fun idea but it trivialises the promise of synthetic biology and glosses over serious ethical and safety issues that the project raises. Adam Zaretsky is a bioartist who is feted within the arts community because he constantly finds himself on the edge of legality. Ironically, the title of one of his recent works the ‘Errorarium’ (a home for zebrafish embryos injected with algae) may reflect his tendency to perpetuate error and misinformation. For example, Zaretsky believes that algae can apparently ‘revert just like E. coli to things like cholera’ – he has previously stated ‘it does happen’.
My own viewpoint is that I do not want to see the door closed on DIY biology, which, at present, can offer a valuable means of public engagement in microbiology and in the future it might make some meaningful scientific impact. However, I do believe that it is important for DIY biologists to seek at least some insight from scientists so their work is safe and may be equally valued by both artists and scientists alike. An exemplar in this movement is Genspace, which has a strict policy against working with organisms that can infect humans and it has established a safety review board of experts from the Massachusetts Institute of Technology, the United States Department of Health and Human Services and other institutions to approve proposals for new experiments.
Simon Park
University of Surrey. Email [email protected].
Further reading
Genspace, New York City’s Community Biolab.
Indie Biotech, an open source biotechnology resource for everyone.
bioCurious, a community biology lab for amateurs, inventors, entrepreneurs.
Microbiology at Home: a short non-laboratory manual for enthusiasts and bioartists.
